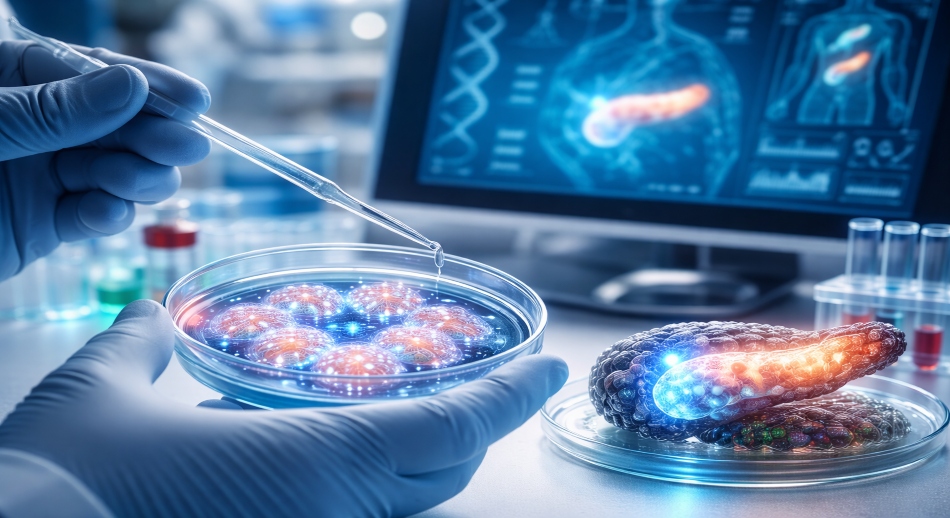

Por primera vez en la historia de la medicina moderna, un avance procedente de China ha abierto la puerta a una posibilidad que durante décadas fue considerada inalcanzable: la reversión de la diabetes tipo 1 y tipo 2 mediante el uso de células madre obtenidas del propio paciente. Este logro no implica aún una cura universal ni inmediata, pero sí marca un punto de inflexión en la forma en que la ciencia entiende y enfrenta una de las enfermedades crónicas más extendidas del mundo. La noticia ha despertado un enorme interés internacional porque desafía la idea tradicional de que la diabetes, especialmente la tipo 1, es irreversible.
La diabetes ha sido históricamente tratada como una condición de manejo continuo y no como una enfermedad curable. En el caso de la diabetes tipo 1, el sistema inmunológico destruye las células beta del páncreas encargadas de producir insulina, obligando al paciente a depender de inyecciones diarias durante toda su vida. La diabetes tipo 2, aunque relacionada con el estilo de vida y la resistencia a la insulina, también suele progresar hasta requerir medicación permanente. Durante años, los tratamientos se han centrado en controlar los niveles de glucosa, no en restaurar la función perdida del organismo.
El avance logrado en China se basa en una estrategia radicalmente distinta. En lugar de introducir células externas o depender de donantes, los investigadores han utilizado células madre del propio paciente, reprogramándolas para que se transformen en células funcionales capaces de producir insulina. Al provenir del mismo organismo, estas células reducen de forma significativa el riesgo de rechazo inmunológico, uno de los mayores obstáculos en los trasplantes tradicionales. Este enfoque personalizado representa una nueva forma de medicina regenerativa, donde el cuerpo se convierte en su propio recurso terapéutico.
Los primeros resultados, obtenidos en ensayos clínicos cuidadosamente controlados, han mostrado que algunos pacientes tratados lograron normalizar sus niveles de glucosa sin necesidad de insulina externa o con una reducción drástica de su uso. En ciertos casos, la función pancreática se recuperó de manera suficiente como para mantener el equilibrio metabólico de forma autónoma. Aunque estos resultados no se han replicado aún a gran escala, su impacto científico es enorme, ya que demuestran que la regeneración del sistema productor de insulina es posible incluso en enfermedades consideradas autoinmunes.
Este avance tiene implicaciones profundas tanto para la diabetes tipo 1 como para la tipo 2. En la primera, el desafío no solo es regenerar las células beta, sino también evitar que el sistema inmunológico vuelva a atacarlas. El uso de células madre autólogas, combinado con técnicas de modificación celular, parece ofrecer una vía para sortear este problema. En la diabetes tipo 2, donde la resistencia a la insulina y el deterioro progresivo del páncreas juegan un papel clave, la regeneración celular podría permitir una recuperación funcional antes impensable.
Más allá de los resultados clínicos iniciales, este logro representa un cambio de mentalidad en la investigación médica. En lugar de tratar los síntomas de forma indefinida, la ciencia comienza a enfocarse en reparar el daño original. La posibilidad de que una enfermedad crónica pueda revertirse utilizando los propios recursos biológicos del paciente redefine el concepto de tratamiento y abre nuevas expectativas para millones de personas en todo el mundo.
Sin embargo, los propios investigadores han subrayado que este avance debe interpretarse con cautela. Los estudios aún se encuentran en fases tempranas, los tratamientos son complejos y costosos, y no todos los pacientes responden de la misma manera. Además, será necesario un seguimiento a largo plazo para confirmar que los efectos se mantienen en el tiempo y que no surgen complicaciones imprevistas. Aun así, el hecho de haber demostrado la viabilidad del enfoque ya constituye un hito histórico.
El impacto potencial de este descubrimiento va más allá de la diabetes. Si la regeneración celular personalizada logra consolidarse, podría aplicarse a otras enfermedades crónicas y degenerativas que hoy no tienen cura. China, con una fuerte inversión en biotecnología y medicina regenerativa, se ha posicionado como un actor clave en esta nueva etapa de la investigación médica, impulsando avances que podrían transformar el futuro de la salud global.
En definitiva, la reversión de la diabetes tipo 1 y tipo 2 mediante células madre del propio paciente no es aún una solución disponible para todos, pero sí una prueba contundente de que lo que antes parecía imposible empieza a ser científicamente alcanzable. Este logro no solo ofrece esperanza a millones de personas que viven con diabetes, sino que también envía un mensaje poderoso: la medicina del futuro no se limitará a controlar enfermedades, sino que buscará restaurar la capacidad natural del cuerpo para sanar.